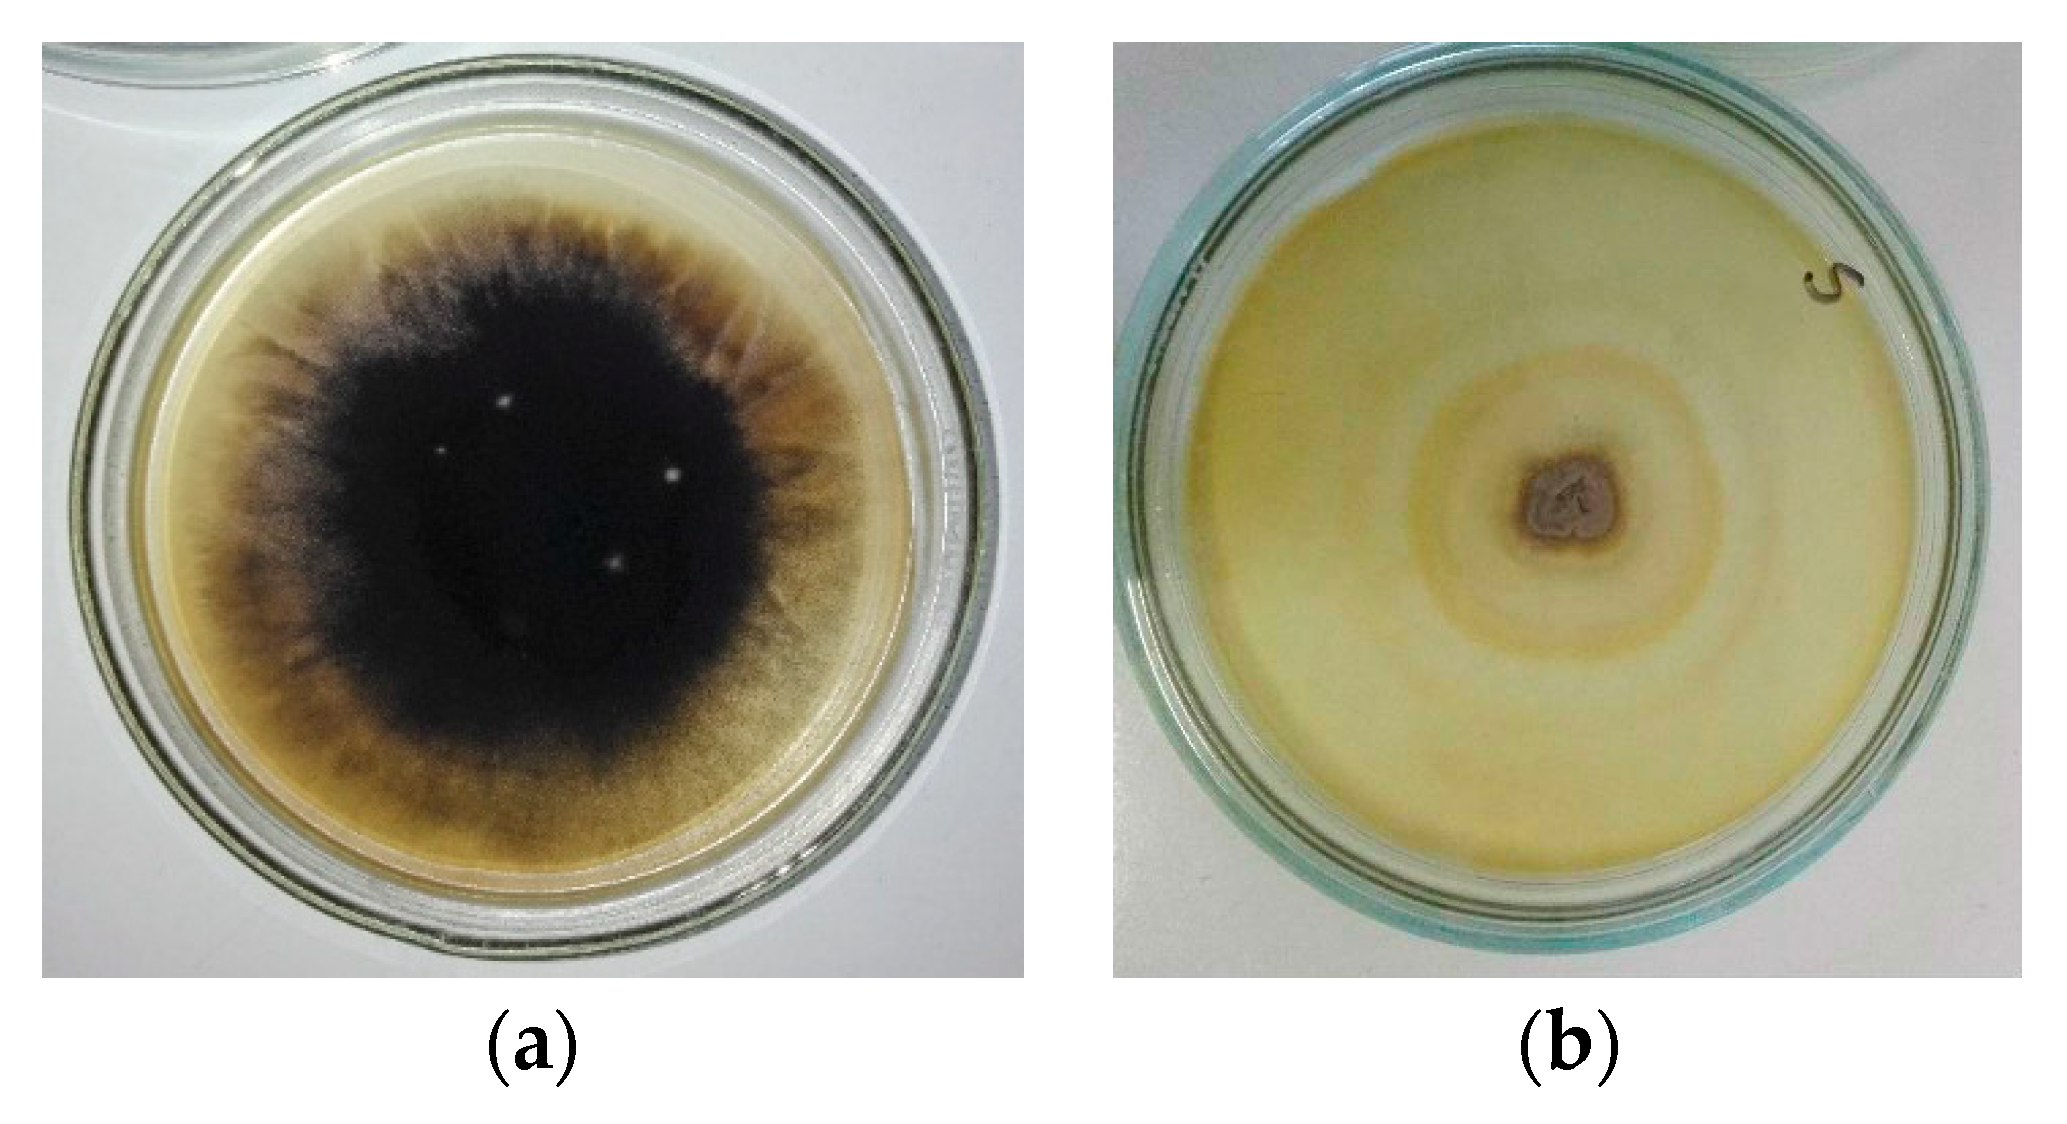
Energies 14 01602 g003 Energies 14 01602 g003

Testing the Toxicity of Stachybotrys chartarum in Indoor Environments—A Case Study
Abstract
1. Introduction
2. Materials and Methods
2.1. Sample Collection and Cultivation
2.2. Cultures of Stachybotrys chartarum
2.3. Methanol Extracts for Ecotoxicological Tests
2.4. Ecotoxicological Tests Using Dugesia Tigrina
2.5. Ecotoxicological Tests Using Daphnia Magna
2.6. Determination of Secondary Metabolites of S. chartarum Using the LC-MS/MS Method
2.7. Statistical Analysis
3. Results
3.1. Results of Mycological Analysis
3.2. Toxicological Tests
3.3. Chromatographic Analysis
4. Discussion
5. Conclusions
Supplementary Materials
Author Contributions
Funding
Institutional Review Board Statement
Informed Consent Statement
Data Availability Statement
Acknowledgments
Conflicts of Interest
References
- Dales, R.E.; Zwanenburg, H.; Burnett, R.; Franklin, C.A. Respiratory health effects of home dampness and molds among Canadian children. Am. J. Epidemiol. 1991, 134, 196–206. [Google Scholar] [CrossRef]
- Hendry, K.M.; Cole, E.C. A review of mycotoxins in indoor air. J. Toxicol. Environ. Health 1993, 38, 138–198. [Google Scholar] [CrossRef] [PubMed]
- Johanning, E.; Gareis, M.; Chin, Y.S.; Hintikka, E.L.; Jarvis, B.B.; Dietrich, R. Toxicity screening of materials from buildings with fungal indoor air quality problems (Stachybotrys chartarum). Mycotoxin Res. 1998, 14, 60–73. [Google Scholar]
- Piontek, M. Grzyby Pleśniowe i Ocena Zagrożenia Mikotoksycznego w Budownictwie Mieszkaniowym (Moulds and Estimation of Mycotoxic Threat in Dwelling Buildings); Wydawnictwo Uniwersytetu Zielonogórskiego: Zielona Góra, Poland, 2004; 174p. [Google Scholar]
- Piontek, M.; Jasiewicz, M.; Bednar, K. Biodeterioracja pleśniowa wywołana występowaniem wad technologicznych w budownictwie (Mould biodeterioration caused by technological defects in dwelling buildings). Ochr. Przed Korozją 2010, 1, 8–13. [Google Scholar]
- Piontek, M.; Jasiewicz, M.; Łuszczyńska, K. Thermal Modernization and Biodeterioration of Prefabricated Elements of Buildings—A Case Study—W: Management of Indoor Air Quality; Dudzińska, M.R., Ed.; Taylor & Francis Group: London, UK, 2011; pp. 109–122. [Google Scholar]
- Piontek, M.; Łuszczyńska, K.; Lechów, H. Occurrence of the toxin-producing Aspergillus versicolor Tiraboschi in residential buildings. Int. J. Environ. Res. Public Health 2016, 13, 862. [Google Scholar] [CrossRef]
- Bloom, E.; Bal, K.; Nyman, E.; Must, A.; Larsson, L. Mass spectrometry-based strategy for direct detection and quantification of some mycotoxins produced by Stachybotrys and Aspergillus spp. in indoor environments. Appl. Environ. Microbiol. 2007, 73, 4211–4217. [Google Scholar] [CrossRef]
- Nielsen, K.F. Mycotoxin production by indoor molds. Fungal Genet. Biol. 2003, 39, 103–117. [Google Scholar] [CrossRef]
- Dearborn, D.G.; Infeld, M.D.; Smith, P.G. Update. Pulmonary hemorrhage/hemosiderosis among infants 1993–1996. Morb. Mortal. Wkly. Rep. 1997, 46, 33–35. [Google Scholar]
- Dearborn, D.G.; Yike, I.; Sorenson, W.G.; Miller, M.J.; Etzel, R.A. Overview of investigations into pulmonary hemorrhage among infants in Cleveland, Ohio. Environ. Health Perspect. 1999, 107 (Suppl. 3), 495–499. [Google Scholar] [CrossRef]
- Vesper, S.J.; Vesper, M.J. Stachylisin may be a cause of hemorrhaging in humans exposed to Stachybotrys chartarum. Infect. Immun. 2002, 70, 2065–2069. [Google Scholar] [CrossRef] [PubMed]
- Samson, R.A.; Hoekstra, E.S.; Frisvad, J.C. Introduction to Food and Airborne Fungi, 7th ed.; Centralbureau voor Schimmercultures (CBS): Utrecht, The Netherlands, 2004; 389p. [Google Scholar]
- Nelson, B.D. Stachybotrys chartarum: The Toxic Indoor Mold. APSnet Features. 2001. Available online: https://www.apsnet.org/edcenter/apsnetfeatures/Pages/Stachybotrys.aspx (accessed on 11 February 2021). [CrossRef]
- Nielsen, K.F.; Holm, G.; Uttrup, L.P.; Nielsen, P.A. Mould growth on building materials under low water activities. Influence of humidity and temperature on fungal growth and secondary metabolism. Int. Biodeterior. Biodegrad. 2004, 54, 325–336. [Google Scholar] [CrossRef]
- Andersen, B.; Thrane, U.; Szaro, T.; Taylor, J.W.; Jarvis, B.B. Molecular and phenotypic descriptions of Stachybotrys chlorohalonata sp. nov. and two chemotypes of Stachybotrys chartarum found in water-damaged buildings. Mycologia 2003, 95, 1227–1238. [Google Scholar] [CrossRef] [PubMed]
- Andersen, B.; Frisvad, J.C.; Søndergaard, I.; Rasmussen, I.S.; Larsen, L.S. Associations between Fungal Species and Water-Damaged Building Materials. Appl. Environ. Microbiol. 2011, 77, 4180–4188. [Google Scholar] [CrossRef] [PubMed]
- Nielsen, K.F. Mould Growth on Building Materials. Secondary Metabolites, Mycotoxins and Biomarkers. Ph.D. Thesis, Hørsholm DK, By og Byg, Statens Byggeforskningsinstitut, Danish Building and Urban Research, Copenhagen, Denmark, 2002; 106p. [Google Scholar]
- Andersen, B.; Nielsen, K.F.; Jarvis, B.B. Characterisation of Stachybotrys from water-damaged buildings based on morphology, growth and metabolite production. Mycologia 2002, 94, 392–403. [Google Scholar] [CrossRef] [PubMed]
- Croft, W.A.; Jarvis, B.B.; Yatawara, C.S. Airborne outbreak of Trichothecene Mycotoxicosis. Atmos. Environ. 1986, 20, 549–552. [Google Scholar] [CrossRef]
- Jarvis, B.B.; Sorenson, W.G.; Hintikka, E.-L.; Nikulin, M.; Zhou, Y.; Jirang, J.; Wang, S.; Hinkley, S.; Etzel, R.A.; Dearborn, D.G. Study of toxin production by isolates of Stachybotrys chartarum and Memnoniella echinata isolated during a study of pulmonary hemosiderosis in infants. Appl. Environ. Microbiol. 1998, 64, 3620–3625. [Google Scholar] [CrossRef] [PubMed]
- Nielsen, K.F.; Thrane, U.; Larsen, T.O.; Nielsen, P.A.; Gravesen, S. Production of mycotoxins on artificially inoculated building materials. Int. Biodeterior. Biodegrad. 1998, 42, 9–16. [Google Scholar] [CrossRef]
- Nielsen, K.F.; Huttunen, K.; Hyvärinen, A.; Andersen, B.; Jarvis, B.B.; Hirvonen, M.-R. Metabolite profiles of Stachybotrys isolates from water-damaged buildings and their induction of inflammatory mediators and cytotoxicity in macrophages. Mycopathologia 2001, 154, 201–205. [Google Scholar] [CrossRef] [PubMed]
- Vesper, S.J.; Dearborn, D.G.; Yike, I.; Allen, T.; Sobolewski, J.; Hinkley, S.F.; Jarvis, B.B.; Haugland, R.A. Evaluation of Stachybotrys chartarum in the house of an infant with pulmonary hemmorrhage: Quantitative assessment before, during, and after Remediation. J. Urban Health 2000, 77, 68–85. [Google Scholar] [CrossRef]
- Hinkley, S.F.; Mazzola, E.P.; Fettinger, J.C.; Lam, Y.K.T.; Jarvis, B.B. Atranones A–G, from the toxigenic mold Stachybotrys chartarum. Phytochemistry 2000, 55, 663–673. [Google Scholar] [CrossRef]
- Došen, I.; Andersen, B.; Phippen, C.B.; Clausen, G.; Nielsen, K.F. Stachybotrys mycotoxins: From culture extracts to dust samples. Anal. Bioanal. Chem. 2016, 408, 5513–5526. [Google Scholar] [CrossRef] [PubMed]
- Pestka, J.J.; Yike, I.; Dearborn, D.G.; Ward, M.D.W.; Harkema, J.R. Stachybotrys chartarum, Trichothecene Mycotoxins, and Damp Building–Related Illness: New Insights into a Public Health Enigma. Toxicol. Sci. 2008, 104, 4–26. [Google Scholar] [CrossRef] [PubMed]
- Jansen, B.J.; de Groot, G.A. Occurrence, biological activity and synthesis of drimane sesquiterpenoids. Nat. Prod. Rep. 2004, 2, 449–477. [Google Scholar] [CrossRef] [PubMed]
- Hasumi, K.; Ohyama, S.; Kohyama, T.; Ohsaki, Y.; Takayasu, R.; Endo, A. Isolation of SMTP-3, 4, 5 and -6, novel analogs of staplabin, and their effects on plasminogen activation and fibrinolysis. J. Antibiot. 1998, 51, 1059–1068. [Google Scholar] [CrossRef] [PubMed]
- Kaneto, R.; Dobashi, K.; Kojima, I.; Sakai, K.; Shibamoto, N.; Yoshioka, T.; Nishid, A.H.; Okamoto, R.; Akagawa, H.; Mizuno, S. Mer-nf5003b, mer-nf5003e and mer-nf5003f, novel sesquiterpenoids as avian-myeloblastosis virus protease inhibitors produced by Stachybotrys sp. J. Antibiot. 1994, 47, 727–730. [Google Scholar] [CrossRef]
- Kohyama, T.; Hasumi, K.; Hamanaka, A.; Endo, A. SMTP-1 and -2, novel analogs of staplabin produced by Stachybotrys microspora IFO30018. J. Antibiot. 1997, 50, 172–174. [Google Scholar] [CrossRef]
- Nozawa, Y.; Yamamoto, K.; Ito, M.; Sakai, N.; Mizoue, K.; Mizobe, F.; Hanada, K. Stachybotrin C and parvisporin, novel neuritogenic compounds. 1. Taxonomy, isolation, physico-chemical and biological properties. J. Antibiot. 1997, 50, 635–640. [Google Scholar] [CrossRef] [PubMed]
- Došen, I.; Andersen, B.; Nielsen, K.F. LC-MS Based Analysis of Secondary Metabolites from Chaetomium and Stachybotrys Growth in Indoor Environments. Ph.D. Thesis, Department of Systems Biology, Technical University of Denmark, Copenhagen, Denmark, 2016; 239p. [Google Scholar]
- Piontek, M. Moulds occurring in buildings of western district of Poland Lubuskie e. In Proceedings of the II Conference on Microbial Biodegradation and Biodeterioration of Technical Materials, Łódź, Poland, 30–31 May 2001; pp. 86–94. [Google Scholar]
- Piontek, M. Moulds occurring in buildings of the Lubuskie province, Poland. Int. Biodeterior. Biodegrad. 2004, 53, 185. [Google Scholar]
- Flannigan, B.; Beardwood, K.; Ricaud, P.M.; Kirsch, J. Growth and toxin production in moulds isolated from houses. In Biodeterioration and Biodegradation; Rossmore, H.W., Ed.; Elsevier: London, UK, 1991; Volume 8, pp. 487–488. [Google Scholar]
- Flannigan, B. Microbial aerosols in buildings: Origin, health implications and controls. In Proceedings of the II Conference on Microbial Biodegradation and Biodeterioration of Technical Materials, Łódź, Poland, 30–31 May 2001; pp. 11–27. [Google Scholar]
- Gravesen, S.; Nielsen, P.A.; Nielsen, K.F. SBI Report 282, Microfungi in Water Damaged Buildings; Danish Building Research Institute: Hørsholm, Denmark, 1997. [Google Scholar]
- Jarvis, B.B.; Nielsen, K.F. Stachybotrys–An Unusual Mold Associated with Water–Damaged Buildings; 22 Mycotoxin–Workshop: Bonn, Germnay, 2000. [Google Scholar]
- Hodgson, M.J.; Morey, P.R.; Leung, W.Y.; Morrow, L.; Miller, J.D.; Jarvis, B.B.; Robbins, H.; Halsey, J.F.; Storey, E. Building–associated pulmonary disease from exposure to Stachybotrys chartarum and Aspergillus versicolor. J. Occup. Environ. Med. 1998, 40, 241–249. [Google Scholar] [CrossRef]
- Nikulin, M.; Reijula, K.; Jarvis, B.B.; Veijalainen, P.; Hintikka, E.-L. Effects on intranasal exposure to spores of Stachybotrys atra in mice. Fundam. Appl. Toxicol. 1997, 35, 182–188. [Google Scholar] [CrossRef] [PubMed]
- Piontek, M. Strains of Aspergillus versicolor Tiraboschi synthesizing sterigmatocistin and the differentiation of mycotoxic risk dependent on their productivity in housing buildings. Mycotoxin Res. 2007, 23, 34–38. [Google Scholar] [CrossRef] [PubMed]
- Hoekstra, E.S.; Samson, R.A.; Summerbell, R.C. Methods for the detection and isolation of fungi in the indoor environments. In Introduction to Food and Airborne Fungi, 7th ed.; Samson, R.A., Hoekstra, E.S., Frisvad, J.C., Eds.; Centralbureau voor Schimmercultures (CBS): Utrecht, The Netherlands, 2004. [Google Scholar]
- Fassatiova, O. Moulds in Technical Microbiology; WNT: Warszawa, Poland, 1983; 255p. [Google Scholar]
- Seifert, K.; Morgan-Jones, G.; Gams, W.; Kendrick, B. The Genera of Hyphomycetes; CBS-KNAW Fungal Biodiversity Centre: Utrecht, The Netherlands, 2011; 997p. [Google Scholar]
- Piontek, M. Moulds Atlas; Wydawnictwo Politechniki Zielonogórskiej: Zielona Góra, Poland, 1999; 113p. [Google Scholar]
- De Hoog, G.S.; Guarro, J. Atlas of Clinical Fungi, 2nd ed.; Centralbureau voor Schimmelcultures (CBS): Utrecht, The Netherlands, 2000. [Google Scholar]
- Pitt, J.I. A Laboratory Guide to Common Penicillium Species, 3rd ed.; Commonwealth Scientific and Industrial Research Organisation: North Ryde, Australia, 2000; 197p. [Google Scholar]
- Samson, R.A.; Houbraken, J.; Thrane, U.; Frisvad, J.C.; Andersen, B. Food and Indoor Fungi; CBS Manual Series 2; CBS KNAW Biodiversity Center: Utrecht, The Netherlands, 2010; 390p. [Google Scholar]
- Piontek, M. Use of planarian Dugesia tigrina Girard bioassay for assessing the toxicity of sterigmatocistin produced by Aspergillus versicolor Tiraboschi. Environ. Prot. Eng. 2010, 36, 65–71. [Google Scholar]
- Piontek, M. The regenerative ability of the planarian Dugesia tigrina (Girard) and the possibility of its use in reproduction of this species. Acta Hydrobiol. 1984, 25, 81–88. [Google Scholar]
- Piontek, M. Application of Dugesia tigrina Girard in toxicological studies of aquatic environments. Pol. Arch. Hydrobiol. 1998, 45, 565–572. [Google Scholar]
- Piontek, M. Use of the planarian Dugesia tigrina Girard in studies of acute intoxication. Pol. Arch. Hydrobiol. 1999, 46, 41–48. [Google Scholar]
- Piontek, M. Use of a planarian Dugesia tigrina Girard in the studies of acute toxicity of organic substances. Pol. Arch. Hydrobiol. 1999, 46, 331–338. [Google Scholar]
- Piontek, M. Application of the Dugesia tigrina Girard bioassay in mycotoxicological investigations. Part, I. Acute toxicity. In Proceedings of the VII International Scientific Conference, Bydgoszcz, Poland, 28–30 June 2004; pp. 149–155. [Google Scholar]
- Weber, E. Grundriss der Biologischen Statistik für Naturwissenschaftler, Landwirte und Mediziner; Jena, G., Ed.; Fischer Verlag: Frankfurt am Main, Germany, 1972; 674p. [Google Scholar]
- Liebmann, H. Handbuch der Frischwasser und Abwasserbiologie. Bd. 1, 2; Jena, G., Ed.; Fischer Verlag: Frankfurt am Main, Germany, 1962; 588p, as cited by Breitig and Tümpling, Ausgewählte Methoden der Wasseruntersuchung, Vol. II; Jena, G., Ed.; Fischer Verlag: Frankfurt am Main, Germany, 1970. [Google Scholar]
- PN-EN ISO 6341. Water Quality. Determination of the Inhibition of the Mobility of Daphnia magna Straus (Cladocera, Crustacea)–Acute Toxicity Test. Available online: https://www.iso.org/standard/54614.html (accessed on 15 October 2012).
- Vishwanath, V.; Sulyok, M.; Labuda, R.; Bicker, W.; Krska, R. Simultaneous determination of 186 fungal and bacterial metabolites in indoor matrices by liquid chromatography/tandem mass spectrometry. Anal. Bioanal. Chem. 2009, 395, 1355–1372. [Google Scholar] [CrossRef]
- Malachová, A.; Suylok, M.; Beltran, E.; Berthiller, F.; Krska, R. Optimization and validation of a quantitative liquid chromatography–tandem mass spectrometric method covering 295 bacterial and fungal metabolites including all regulated mycotoxins in four model food matrices. J. Chromatogr. A 2014, 1362, 145–156. [Google Scholar] [CrossRef]
- SANTE/12089/2016. Guidance Document on Identification of Mycotoxins in Food and Feed. Available online: https://ec.europa.eu/food/sites/food/files/safety/docs/cs_contaminants_sampling_guid-doc-ident-mycotoxins.pdf (accessed on 1 January 2017).
- Stadler, D.; Sulyok, M.; Schuhmacher, R.; Berthiller, F.; Krska, R. The contribution of lot-to-lot variation to the measurement uncertainty of an LC-MS-based multi-mycotoxin assay. Anal. Bioanal. Chem. 2018, 410, 4409–4418. [Google Scholar] [CrossRef]
- Urlich, S.; Schäfer, C. Toxin Production by Stachybotrys chartarum Genotype S on Different Culture Media. J. Fungi 2020, 6, 159. [Google Scholar] [CrossRef]
- Gaylarde, C.; Otlewska, A.; Celikkol-Aydin, S.; Skóra, J.; Sulyok, M.; Pielech-Przybylska, G.J.; Beech, I.; Gutarowska, B. Interactions between fungi of standard paint test method BS3900. Int. Biodeterior. Biodegrad. 2015, 104, 411–418. [Google Scholar] [CrossRef]
- Johanning, E.; Biagini, R.E.; Hull, D.; Morey, P.R.; Jarvis, B.B.; Landsbergis, P. Health and immunology study following exposure to toxigenic fungi (Stachybotrys chartarum) in a waterdamaged office environment. Int. Arch. Occup. Environ. Health 1996, 68, 207–218. [Google Scholar] [PubMed]
- Anderson, M.A.; Nikulin, M.; Köljalg, U.; Anderson, M.C.; Rainey, F.; Reijula, K.; Hintikka, E.-L.; Salkinoja-Salonen, M. Bacteria, moulds, and toxins in water-damaged building materials. Appl. Environ. Microbiol. 1997, 63, 387–393. [Google Scholar] [CrossRef]
- Nielsen, K.F.; Gravesen, S.; Nielsen, P.A.; Andersen, B.; Thrane, U.; Frisvad, J.C. Production of mycotoxins on artificially and naturally infested building materials. Mycopathologia 1999, 45, 43–56. [Google Scholar] [CrossRef] [PubMed]
- Cole, R.J.; Cox, R.H. Handbook of Toxic Fungal Metabolites; Academic Press: New York, NY, USA, 1981; 937p. [Google Scholar]
- Steyn, P.S.; Rabie, C.J. Characterisation of magnesium and calcium tenuazonate from Phoma sorgina. Phytochemistry 1976, 15, 1977–1979. [Google Scholar] [CrossRef]
- Gutarowska, B. Grzyby Strzępkowe Zasiedlające Materiały Budowlane: Wzrost Oraz Produkcja Mikotoksyn i Alergenów (Filamentous Fungi Colonizing Building Materials: Growth and Production of Mycotoxins and Allergens); Zeszyty Naukowe Politechniki Łódzkiej Nr 1074; Politechnika Łódzka: Łódź, Poland, 2010. [Google Scholar]
- Piecková, E.; Hurbánková, M.; Černá, S.; Pivovarová, Z.; Kováčiková, Z. Pulmonary cytotoxicity of secondary metabolites of Stachybotrys chartarum (Ehrenb.) Hughes. Ann. Agric. Environ. Med. 2006, 13, 259–262. [Google Scholar]

| Result of Toxicity Test–LC 50 Value (mg∙L−1) | Toxicity Classes | Classes |
|---|---|---|
| <1 | highly toxic | I |
| 1–10 | potently toxic | II |
| 10–100 | moderately toxic | III |
| 100–1000 | slightly toxic | IV |
| >1000 | barely toxic | V |
| No. | Sampling Place | Coexisting Moulds and Organisms | Wall Finishing Material | Wall Humidity [%] | Air Humidity [%] |
|---|---|---|---|---|---|
| 1. | Palace in Rakow, Poland | Stachybotrys chartarum, Ulocladium botrytis, Penicillium chrysogenum, Bacteria | glue paint | 8 | 72 |
| 2. | Building of UZ, Zielona Góra, Poland | Stachybotrys chartarum, Penicillium chrysogenum, Actinobacteria Bacteria | acrylic paint | 10 | 65 |
| 3. | Tenement house, Poland | Stachybotrys chartarum *, Penicillium chrysogenum, Mucor hiemalis Bacteria | acrylic paint | 11 | 53 |
| 4. | Scout’s house, Zielona Góra, Poland | Stachybotrys chartarum, Penicillium chrysogenum, Actinobacteria Bacteria | wallpaper | 10 | 58 |
| Type of Medium/Bioindicator | LC 50 [mg∙L−1] | Toxicity Class According to Liebmann |
|---|---|---|
| PDA | ||
| D. tigrina | 67.6 | class III (moderately toxic) |
| D. magna | 75.9 | class III (moderately toxic) |
| MEA | ||
| D. tigrina | 169.8 | class IV (slightly toxic) |
| D. magna | 190.5 | class IV (slightly toxic) |
| Metabolites of Stachybotrys chartarum | S. chartarum on PDA [ng/g] | S. chartarum on MEA [ng/g] |
|---|---|---|
| Metabolites Reported for Stachybotrys in Antibase | ||
| Stachybotryamide | 109,000 | 62,500 |
| Stachybotrylactam | 27,100 | 46,300 |
| Antibiotic F 1839A | 6470 | 10,200 |
| Aurantine | 67.1 | <LOD |
| Orsellinic acid | 21,500 | <LOD |
| Unspecific metabolites | ||
| Asperglaucide | <LOD | <LOD |
| Brevianamid F | 62.7 | 1697 |
| Cyclo(L-Pro-L-Tyr) | 136 | 252,200 |
| Cyclo(L-Pro-L-Val) | 583 | 66,420 |
| N-benzoyl-Phenylalanine | 4.07 | <LOD |
| Rugulusovin | 21.8 | 375 |
| Tenuazonic acid | <LOD | 48.7 |
| Tryptophol | <LOD | <LOD |
Publisher’s Note: MDPI stays neutral with regard to jurisdictional claims in published maps and institutional affiliations. |
© 2021 by the authors. Licensee MDPI, Basel, Switzerland. This article is an open access article distributed under the terms and conditions of the Creative Commons Attribution (CC BY) license (http://creativecommons.org/licenses/by/4.0/).
Share and Cite
Piontek, M.; Łuszczyńska, K. Testing the Toxicity of Stachybotrys chartarum in Indoor Environments—A Case Study. Energies 2021, 14, 1602. https://doi.org/10.3390/en14061602
Piontek M, Łuszczyńska K. Testing the Toxicity of Stachybotrys chartarum in Indoor Environments—A Case Study. Energies. 2021; 14(6):1602. https://doi.org/10.3390/en14061602
Chicago/Turabian StylePiontek, Marlena, and Katarzyna Łuszczyńska. 2021. "Testing the Toxicity of Stachybotrys chartarum in Indoor Environments—A Case Study" Energies 14, no. 6: 1602. https://doi.org/10.3390/en14061602
APA StylePiontek, M., & Łuszczyńska, K. (2021). Testing the Toxicity of Stachybotrys chartarum in Indoor Environments—A Case Study. Energies, 14(6), 1602. https://doi.org/10.3390/en14061602

